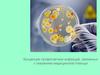
Концепция профилактики инфекций, связанных с оказанием медицинской помощи

Похожие презентации:
Организация проведения научных исследований в медицине. Концепция развития медицинской науки до 2020 года в РК
1. Организация проведения научных исследований в медицине . Концепция развития медицинской науки до 2020 года в РК
НАО «Медицинский университет Астана»Кафедра менеджмента и экспертной деятельности в здравоохранении
Организация проведения научных
исследований в медицине .
Концепция развития медицинской науки
до 2020 года в РК
Выполнила: Бектаева А. 138-Д
Проверил: к.м.н. Доцент Айгужин Б.К.
Астана – 2019 год
1
2. Содержание:
1.2.
3.
a.
b.
c.
d.
Организация проведения научных исследований в медицине
Цель концепции
Задачи концепции
Задача 1. Совершенствование менеджмента на всех уровнях
научно-инновационного процесса
Задача 2. Развитие научной и инновационной
инфраструктуры системы здравоохранения
Задача 3. Повышение качества подготовки научных кадров,
развитие научного и инновационного потенциала
работников организаций здравоохранения
Формирование эффективной системы продвижение
научных разработок и инноваций в практическое
здравоохранение и мировое исследовательское
пространство
2
3.
Научное исследование —процесс изучения, эксперимента, концептуализа
ции и проверки теории, связанной с
получением научных знаний.
Компетенция государственных органов в области
научной и (или) научно-технической деятельности
Закон Республики Казахстан от 18 февраля 2011
года № 407-IV «О науке» (с изменениями и
дополнениями по состоянию на 13.11.2015 г.)
3
4.
Цель научного исследования- определениеконкретного объекта и всестороннее,
достоверное изучение его структуры,
характеристик, связей на основе
разработанных в науке принципов и
методов познания, а также получение
полезных для деятельности человека
результатов, внедрение в производство с
дальнейшем эффектом.
4
5.
Принцип научного исследования:Выдвижение гипотезы
Планирование исследования
Проведение исследования
Опровержение или неопровержение
гипотезы
В случае опровержения старойформулирование новой гипотезы
5
6.
Иерархия управления научной и научноисследовательской деятельностью в РКПравительство РК
МЗ РК
Уполномоченный
орган
Национальная
академия наук РК
МОНРК
ВУЗы
6
7. Правительство Республики Казахстан:
1.2.
3.
4.
5.
разрабатывает основные направления государственной
политики в области науки и научно-технической
деятельности и организует ее осуществление;
определяет приоритетные направления научной,
научно-технической и инновационной деятельности в
соответствии
с
приоритетами
социальноэкономического развития;
вносит Президенту Республики Казахстан ежегодный
национальный доклад по науке;
утверждает правила аккредитации субъектов научной и
(или) научно-технической деятельности;
создает
Высшую
научнотехническую комиссию Республики Казахстан при
Правительстве Республики Казахстан и утверждает
ее положение и состав;
8. В компетенцию уполномоченного органа входят:
1.2.
3.
4.
координация
научных,
научно-технических
проектов и программ фундаментальных и
прикладных
научных
исследований,
финансируемых из государственного бюджета;
разработка
приоритетных
направлений
фундаментальных
и
прикладных
научных
исследований в Республике Казахстан;
обеспечение деятельности Высшей научнотехнической комиссии;
разработка правил организации и проведения
государственной
научно-технической
экспертизы;
9.
Научная деятельность высших учебныхзаведений
1. Основным видом деятельности, осуществляемой высшим
учебным заведением, наряду с образовательной является: научная,
научно-техническая и инновационная, в том числе реализация права
на объекты интеллектуальной собственности, а также проведение
научно-исследовательских и опытно-конструкторских работ.
2. Высшие учебные заведения, а также их научные работники
имеют равное право на пользование услугами научных лабораторий
коллективного пользования, участие в конкурсах научных, научнотехнических проектов и программ, финансируемых из
государственного бюджета и иных источников, не запрещенных
законодательством Республики Казахстан.
3. Высшие учебные заведения наряду с внедрением в учебный
образовательный процесс передовых достижений науки вправе
привлекать к процессу обучения ученых научных, научноисследовательских организаций, в том числе зарубежных.
4. Государственные высшие учебные заведения вправе создавать
научные лаборатории, научно-исследовательские институты,
опытные производства.
5. Высшим учебным заведениям Правительством Республики
Казахстан может быть присвоен статус исследовательского
университета по представлению уполномоченного органа.
9
10.
Исследовательский университет1. Исследовательский университет является высшим учебным
заведением, реализующим утвержденную Правительством
Республики Казахстан программу развития университета и
участвующим в организации и проведении фундаментальных и
прикладных научных исследований и иных научно-технических,
опытно-конструкторских работ.
2. Основной задачей исследовательского университета является
интеграция научной деятельности и образовательного процесса на
всех уровнях высшего и послевузовского образования.
3. Исследовательский университет самостоятельно разрабатывает
и реализует стандарты образовательных программ высшего и
послевузовского образования. Требования к условиям реализации и
результатам освоения образовательных программ не могут быть ниже
соответствующих программ высшего и послевузовского образования,
устанавливаемых государственными стандартами.
4. Исследовательский университет вправе устанавливать
дополнительные требования профильной направленности при
приеме на обучение по программам высшего и послевузовского
образования.
10
11.
Приказ МЗРК № 485 от 23.08.2013 г.«Концепция развития медицинской науки
до 2020 года»
11
12.
Конце́пция Концепция, или концепт, (от лат. conceptio —понимание, система) — определенный способ
понимания (трактовки) какого-либо предмета,
явления или процесса; основная точка зрения на
предмет; руководящая идея для их
систематического освещения.
Концепция — это определенная система
связанных между собою и вытекающих один из
другого взглядов, способов понимания и трактовки
явления, предмета или процесса, система
достижения целей.
12
13.
Концепция развития медицинской науки до2020 года разработана в соответствии со
Стратегией развития Казахстана «Казахстан - 2050»
Стратегией вхождения Казахстана в число 50-ти
наиболее конкурентоспособных стран мира
Стратегическим планом развития Республики Казахстан
до 2020 года
Государственной программой развития
здравоохранения Республики Казахстан «Саламатты
Қазақстан» на 2011-2015 годы
Концепцией инновационного развития Республики
Казахстан до 2020 года
законами Республики Казахстан «О науке» и «О
государственной поддержке индустриальноинновационной деятельности» в целях определения
основных направлений дальнейшего развития науки и
инноваций в сфере здравоохранения Казахстана до
2020 года.
13
14. Сильные стороны
• наличие сети профильных организаций медицинской науки, создание 4современных научных центров в структуре Национального медицинского
холдинга и лабораторий коллективного пользования на базе 2 медицинских
университетов;
• повышение самостоятельности организаций медицинской науки;
• интенсивное развитие информационных технологий во всех сферах, включая
медицину и науку, доступ к полнотекстовым научным журналам и базам
данных;
• внедрение международных подходов в подготовке научных кадров в системе
здравоохранения - в магистратуре и PhD докторантуре;
• создание научных кластеров и инновационных консорциумов в организациях
медицинской науки;
• создание научных лабораторий коллективного пользования при медицинских
ВУЗах.
14
15. Слабые стороны
недостаточная материально-техническая база
организаций медицинской науки, кафедр и научных
подразделений медицинских ВУЗов;
низкая конкурентоспособность и малая востребованность
результатов научных разработок отечественных ученых,
низкий уровень публикуемости отечественных ученых в
зарубежных рецензируемых журналах,
невостребованность казахстанских журналов за рубежом;
неэффективный менеджмент научных исследований;
низкое качество составления научных проектов и заявок;
недостаточная интеграция медицинского образования,
науки и практики;
низкий уровень привлечения высококвалифицированных
специалистов практического здравоохранения в научные
исследования и разработки;
отсутствие механизмов привлечения молодых
специалистов в научно-исследовательский процесс;
15
16.
Цель: Достижение конкурентоспособности ивосстребованности разработок в сфере
отечественной медицинской и фармацевтической
науки и внедрение на их основе передовых
медицинских технологий и инноваций,
обеспечивающих сохранение и улучшение здоровья
населения Республики Казахстан.
16
17. Задачи:
1) совершенствование менеджмента на всехуровнях научно-инновационного процесса;
2) развитие научной и инновационной
инфраструктуры системы здравоохранения;
3) повышение качества подготовки научных кадров,
развитие научного и инновационного потенциала
работников организаций здравоохранения;
4) формирование эффективной системы
продвижения научных разработок и инноваций в
практическое здравоохранение и мировое
исследовательское пространство.
17
18. Реализация Концепции основывается на следующих принципах:
формирование эффективной системы адресной поддержки
научной и инновационной деятельности в
здравоохранении;
развитие институционального потенциала системы
медицинской и фармацевтической науки и инноваций в
здравоохранении, потенциала научных организаций,
исследовательских коллективов и отдельных
исследователей;
формирование приоритетов научного и инновационного
развития отрасли на основе прогнозирования
потребностей отечественного здравоохранения;
развитие восприимчивости организаций здравоохранения
всех уровней к инновациям;
Сроки реализации - 2013-2020 годы
(первый этап - 2013-2016 гг., второй этап
- 2017-2020 гг.).
18
19.
На 1-м этапе реализацииКонцепции будет
обеспечено
совершенствование
менеджмента на всех
уровнях научноинновационного
процесса, приняты меры
по развитию научной и
инновационной
инфраструктуры,
повышению качества
подготовки научных
кадров, формированию
условий для интеграции
медицинской и
фармацевтической науки,
образования и практики
На 2-м этапе
реализации
Концепции будут
осуществлены меры
по улучшению
качества и
повышению
конкурентоспособнос
ти научных
разработок и
инноваций в области
здравоохранения.
19
20. Задача 1. Совершенствование менеджмента на всех уровнях научно-инновационного процесса
предусматривает:• развитие эффективных технологий
управления научной и инновационной
деятельностью,
• внедрение международных стандартов
научных исследований,
• совершенствование финансирования
научной и инновационной деятельности в
системе здравоохранения
20
21. Развитие эффективных технологий управления научной и инновационной деятельностью в системе здравоохранения предусматривает:
дальнейшее развитие современных принципов и
эффективных механизмов управления наукой в секторе
здравоохранения;
внедрение единых индикаторов оценки результатов
научно-исследовательских работ, системы рейтинговой
оценки научных организаций;
внедрение системы выбора приоритетов научных
исследований в области здравоохранения;
создание национальной обсерватории по научным
исследованиям и опытно-конструкторским разработкам в
области здравоохранения (далее - Обсерватория) для
отслеживания и мониторинга биомедицинских
исследований и разработок.
21
22. Внедрение международных стандартов научных исследований предусматривает:
разработку и внедрение процедуры аккредитации
научных организаций и организаций здравоохранения в
качестве баз для проведения доклинических и
клинических исследований;
дальнейшее развитие практики аттестации
исследовательских лабораторий на соответствие
международным стандартам качества и (или) требованиям
GLP;
совершенствование нормативно-правовой базы в сфере
науки в части внедрения общеобязательной процедуры
этической экспертизы и усиления роли центральной и
локальных этических комиссий, включая их аккредитацию;
внедрение независимой сертификации специалистов
системы здравоохранения по стандартам GLP и GCP как
обязательной процедуры для допуска к доклиническим и
клиническим исследованиям
22
23. Совершенствование финансирования научной и инновационной деятельности в системе здравоохранения предусматривает:
расширение механизмов привлечения
альтернативных источников финансирования
науки и инноваций, в том числе посредством
действующих в стране механизмов
государственно-частного партнерства
создание в организациях медицинской науки и
ВУЗах «Офисов коммерциализации»;
развитие практики софинансирования и
самофинансирования научных исследований в
организациях медицинской науки за счет
средств, полученных от коммерциализации
научных разработок и инновационных проектов.
23
24. Основными критериями для оценки и мониторинга реализации данной задачи Концепции будет достижение следующих индикаторов:
Ед.изм.
-
2012
87
до
2016
60
до
2020
20
Создание национальной обсерватории по научным
исследованиям и опытно-конструкторским разработкам в
области здравоохранения
Количество исследовательских лабораторий,
сертифицированных на соответствие международным
стандартам качества и (или) требованиям GLP
ед.
-
1
1
ед.
3
6
10
Количество организаций здравоохранения,
аккредитованных в качестве клинических баз для
проведения клинических исследований
ед.
-
10
30
%
0
25
100
Количество научных проектов, реализуемых на грантовой
основе
Количество «офисов коммерциализации» в организациях
медицинской науки
ед.
28
50
70
ед.
-
2
6
Количество научных и инновационных программ,
реализуемых на внебюджетной основе
ед.
14
25
35
Количество полученных грантов от зарубежных
грантодателей
ед.
3
10
20
Наименование индикатора
Количество научно-исследовательских и научнопедагогических кадров в расчете на 1 статью в
международных рецензируемых изданиях
Удельный вес локальных этических комиссий, имеющих
аккредитацию
24
25. Задача 2. Развитие научной и инновационной инфраструктуры системы здравоохранения
предусматривает:• формирование и развитие современных
форм научной и инновационной
инфраструктуры,
• внедрение эффективных механизмов
методологического и информационного
сопровождения научной и инновационной
деятельности
25
26. 1) Формирование и развитие современных форм научной и инновационной инфраструктуры предусматривает:
включение научных организаций и ВУЗов в
работу создаваемых на национальном и
региональном уровне инновационных кластеров,
технологических и научных парков, бизнесинкубаторов и старт-апов;
формирование и развитие университетских
клиник - как центров проведения
биомедицинских научных исследований,
внедрения современных достижений медицины;
получение отечественными медицинскими
ВУЗами статуса исследовательских
университетов.
26
27. 2) Внедрение эффективных механизмов методологического и информационного сопровождения научной и инновационной деятельности в
дальнейшее развитие в научных организациях и ВУЗах
подразделений, обеспечивающих методологическое и
информационное сопровождение научного процесса
(отделы/сектора менеджмента научных исследований,
биостатистики, клинической эпидемиологии,
доказательной медицины, патентно-информационной
работы);
обеспечение доступа научных организаций и ВУЗов,
научных коллективов и исследователей к электронным
информационным ресурсам ведущих провайдеров
мировой научно-технической информации;
27
28. Основными критериями для оценки и мониторинга реализации данной задачи Концепции будет достижение следующих индикаторов:
Наименование индикатораЕд.
изм.
201
2
до
2016
до
2020
Удельный вес организаций медицинской науки и
ВУЗов, включенных в работу инновационных
кластеров, технологических и научных парков,
бизнес-инкубаторов, старт-апов
%
-
25
75
Количество медицинских ВУЗов, имеющих
собственные университетские клиники
ед.
2
5
5
Количество медицинских ВУЗов, имеющих статус
исследовательского университета
ед.
-
-
2
Создание реестра научных работников и
инновационно-активных специалистов системы
здравоохранения
Формирование базы данных научных разработок
и инновационных достижений в сфере
здравоохранения
ед.
-
1
1
ед.
-
1
1
28
29. Задача 3. Повышение качества подготовки научных кадров, развитие научного и инновационного потенциала работников организаций
предусматривает:совершенствование программ подготовки и
непрерывного профессионального
развития (далее - НПР) научных работников
внедрение эффективных механизмов
мотивации исследователей и вовлечения
молодежи в научные исследования:
29
30. 1) Совершенствование качества подготовки и НПР научных работников предусматривает:
разработку и внедрение типовых учебных планов и программ
магистратуры и докторантуры PhD, обеспечивающих развитие
ключевых компетенций научного работника;
увеличение объемов подготовки магистров и докторов PhD и
расширение количества специальностей и направлений подготовки;
внедрение системного подхода к НИР, основанного на развитии
ключевых компетенций научного работника;
внедрение специализированных программ подготовки управленцев в
области науки в рамках программ магистратуры и докторантуры и
формирование эффективной системы переподготовки и повышения
квалификации руководителей научных организаций по вопросам
менеджмента.
разработку и внедрение широкого спектра программ дистанционного
и электронного обучения - e-learning;
дальнейшее развитие практики прохождения отечественными учеными
стажировок, в том числе в рамках программ пост-докторантуры (PostDoctoral Research Fellowship Programs) в ведущих зарубежных научных
организациях
30
31. 2) Внедрение эффективных механизмов мотивации исследователей и вовлечения молодежи в научные исследования предусматривает:
дальнейшее развитие и совершенствование в
медицинских ВУЗах сети студенческих научных
кружков и обществ молодых ученых в НИИ, НЦ и
ВУЗах;
внедрение широкого спектра мер материальной и
нематериальной стимуляции отдельных
исследователей и исследовательских коллективов,
включая персонифицированную дифференциальную
систему оплаты труда;
включение научно-ориентированных подходов в
образовательные программы всех уровней
медицинского образования (Research-based
Learning, Project-Based Learning);
31
32. Основными критериями для оценки и мониторинга реализации данной задачи Концепции будет достижение следующих индикаторов:
Наименование индикатораЕд.
изм.
201
2
до
2016
до
2020
Увеличение доли научных кадров, обученных
менеджменту и стандартам научных
исследований
Количество мест, выделяемых ежегодно на
обучение в докторантуре PhD по медицинским
специальностям
Количество мест, выделяемых ежегодно на
обучение в магистратуре по медицинским
специальностям
Удельный вес публикаций в международных
рецензируемых журналах в общем количестве
публикаций
Удельный вес студентов, интернов,
резидентов, привлеченных к реализации
научных и исследовательских программ и
проектов
Доля научных сотрудников до 39 лет
%
30
50
95
чел.
30
100
80
чел.
150
400
350
чел.
3,2
8
15
%
0,1
5
20
%
40,7
49
55
%
0,5
5
20
Удельный вес обучающихся (студентов,
интернов, резидентов, магистрантов,
докторантов), принимающих участие в работе
32
33. Задача 4. Формирование эффективной системы продвижение научных разработок и инноваций в практическое здравоохранение и мировое
предусматривает:внедрение эффективных механизмов
привлечения инноваций из-за рубежа и
трансферта разработок отечественных ученых в
практическое здравоохранение
создание условий для интеграции казахстанской
медицинской науки в мировое научное
пространство:
33
34. 1) Внедрение эффективных механизмов привлечения инноваций из-за рубежа и трансферта разработок отечественных ученых в
совершенствование нормативно-правовой
базы в сфере научно-медицинской
экспертизы, оценки медицинских технологий
и применения новых методов диагностики,
лечения и медицинской реабилитации;
развитие системы проведения
трансляционных исследований в области
здравоохранения;
дальнейшее развитие практики выведения на
рынок медицинских услуг научных
разработок отечественных исследователей.
34
35. 2) Создание условий для интеграции казахстанской медицинской науки в мировое научное пространство предусматривает:
расширение участия научно-исследовательских
организаций и ВУЗов в международных исследовательских
программах;
повышение требований к международным конференциям
на территории РК с широким привлечением к их
проведению ведущих зарубежных специалистов;
развитие казахстанских научных изданий по
общепринятой в международной практике модели
«международного рецензируемого журнала» с
вхождением в международные базы научных изданий.
вхождение медицинских ВУЗов и научных организаций в
авторитетные мировые университетские рейтинги и
мировые рейтинги публикационной активности научных
организаций.
35
36. Основными критериями для оценки и мониторинга реализации данной задачи Концепции будет достижение следующих индикаторов:
Наименование индикатораЕд.
изм.
2012
до
2016
до 2020
Количество новых медицинских технологий, ввозимых в страну
ежегодно (прошедших процедуру ОМТ)
ед.
21
30
50
Количество трансляционных исследований выполняемых в
системе здравоохранения РК
ед.
-
16
33
%
60
80
100
ед.
-
10
20
ед.
8
15
33
Удельный вес научных сотрудников с активным индексом
цитирования
%
0,5
5
15
Удельный вес международных патентов в общем количестве
патентов
%
2,2
4
7
ед.
0
1
6
%
0
10
40
ед.
-
-
1
Удельный вес научных организаций клинического профиля и
ВУЗов (университетских клиник), осуществляющих на
регулярной основе внедрение и трансферт новых технологий в
регионы
Количество научных разработок отечественных ученых,
разрешенных к применению Уполномоченным органом
(ежегодный показатель)
Количество научных и инновационных проектов, реализуемых
с участием зарубежных организаций
Количество организаций медицинской науки, входящих в
авторитетные мировые рейтинги публикационной активности
Удельный вес казахстанских научных изданий в области
здравоохранения, индексируемых в международных
библиометрических базах данных
Количество медицинских ВУЗов Казахстана, отмеченных в
рейтинге лучших мировых университетов
36
37. Этапы научного исследования
предплановыеисследования, составление
и утверждение плана НИР
процесс исследования (сбор материалов,
характеризующих изучаемую проблему, накопление
фактических данных о ней, их систематизация,
выработка определенных представлений о проблеме)
оформление результатов
научного поиска
(интерпретация, отчет,
публикация)
37
38. Выбор темы исследования
Крайне сложный творческий процесс, во многомобеспечивающий успех научной деятельности. Поскольку
выполнение научных исследований требует больших
материально-технических и временных затрат, творческих
усилий, выбор научной темы представляется важнейшим
этапом НИР.
Выбор темы исследования целесообразно начинать
с изучения опыта предшествующих поколений ученых. С
этой целью необходимо изучить исследуемую проблему не
только по источникам литературы, но и овладеть
современной
методической
базой,
знать,
какие
исследования проводятся в ведущих научных школах
мира. Таким образом, на первом этапе планирования
главное — исключить возможность дублирования и
обеспечить достаточно высокий уровень собственных
знаний по определенной проблеме. На втором этапе
планирования следует найти оригинальный подход в
постановке задачи исследования, а затем и в ее решении,
используя новые методические подходы, области их
использования и т.д.
38
39. Тема НИР должна отличаться:
новизной исследуемого вопроса иполучаемых результатов
актуальностью
научно-практической значимостью
доказательностью выдвигаемых
исследователем положений, вытекающих из
полученных результатов.
39
40. Клинические исследования проводятся в следующих случаях:
1.2.
3.
4.
по решению уполномоченного органа при
необходимости получения дополнительных
сведений о безопасности и эффективности
испытуемых образцов;
разработки новых оригинальных лекарственных
средств отечественными производителями;
исследования новых показаний к применению,
изменения лекарственной формы, дозирования
и способа применения;
исследования в рамках международных
многоцентровых клинических исследований (3 и
4 фазы исследований).
40
41. Порядок определения медицинских организаций для проведения клинических исследований
Медицинская
организация
должна
отвечать
необходимым
требованиям, по проведению клинических исследований и (или)
испытаний фармакологических и лекарственных средств, изделий
медицинского назначения и медицинской техники.
Экспертизу
медицинской
организации
на
соответствие
установленным
требованиям
по
проведению
клинических
исследований проводит экспертная организация.
При медицинской организации создается комиссия по вопросам
этики, которая проводит оценку этических и нравственно-правовых
аспектов проведения клинического испытания. Деятельность
комиссии
регламентируется
законодательством
Республики
Казахстан, международными правилами и межгосударственными
соглашениями (Хельсинская декларация Всемирной ассоциации
врачей) в области здравоохранения.
Перечень клинических баз может пересматриваться по мере
необходимости по решению уполномоченного органа.
41
42. Литература
https://online.zakon.kz/Document/?doc_id=31445279
http://adilet.zan.kz/rus/docs/Z1100000407
42










































 Медицина
Медицина Образование
Образование